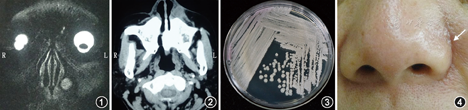

版权归中华医学会所有。
未经授权,不得转载、摘编本刊文章,不得使用本刊的版式设计。
除非特别声明,本刊刊出的所有文章不代表中华医学会和本刊编委会的观点。
患者女,58岁,因发现左侧鼻唇沟肿物伴反复红肿1年余于2015年2月25日以鼻前庭囊肿伴感染入院。患者1年前发现左侧鼻唇沟肿物,约花生米大小,质韧,伴左侧面部及左下眼睑肿胀,局部皮肤充血肿胀,轻度压痛,无破溃,无鼻塞。就诊于当地医院,口服抗生素(具体药物及剂量不详)治疗,面部肿胀消失。后同一部位无明显诱因反复肿胀7~8次,均行口服抗生素治疗,症状缓解。1个月前,无明显诱因左侧鼻唇沟再次出现肿物,伴左下眼睑、左面部及左侧颌下区红肿,轻度疼痛,无破溃,不伴鼻塞,就诊于当地医院,给予口服头孢呋辛酯片规律治疗2周,疼痛及肿胀无明显缓解,遂就诊于我院,门诊行血常规、尿常规、快速C反应蛋白、血生化、感染筛查、抗中性粒细胞胞质抗体(anti-neutrophil cytoplasmic antibodies,ANCA)、抗核抗体(anti-nuclear immune body,ANA)等检查。快速C反应蛋白24 mg/L(正常值0~10 mg/L),余结果均无异常,同时给予盐酸莫西沙星片0.4 g,每日1次,口服1周,症状无明显好转,遂行头颅MRI(图1)示:左侧鼻翼后方、鼻腔左侧软组织内可见一类圆形T2W1高信号结节,直径约1.1 cm,边界清晰。鼻窦CT(图2)示:左鼻前庭内可见类圆形结节,直径约1 cm,边界尚清。面部B超示:左面部软组织内可见一大小约1 cm低回声结节(脓肿),边界欠清,周边可探及较丰富血流,提示鼻前庭囊肿伴感染。经鼻前庭穿刺抽出2 ml脓性分泌物,培养结果回报:近平滑假丝酵母。结合各项检查初步诊断:鼻前庭囊肿合并真菌感染。门诊给予氟康唑胶囊治疗,第1日150 mg,每日2次,第2日起150 mg,每日1次,口服7 d,面部肿胀减轻,肿物明显缩小,于2015年2月25日收入院。入院检查:外鼻无畸形,鼻梁居中,无塌陷,左侧鼻唇沟变浅可触及一直径约1 cm肿物,表面皮肤充血肿胀,肿胀范围约2 cm×2 cm,表面无破溃,触之质韧,皮温无明显升高,无压痛,肿物与皮肤粘连,活动度欠佳,左鼻前庭外下方隆起,表面皮肤正常,左前鼻孔挤压变窄,鼻腔检查未见新生物、未见脓性分泌物。患者平素体健,无高血压及糖尿病病史,有足癣史10余年(反复发作,未愈)。入院诊断为鼻前庭囊肿合并真菌感染。

入院后第1天全麻下行"鼻前庭肿物切除术"。手术经鼻外入路,沿鼻唇沟肿物表面周边行梭形切口,逐层分离,见肿物有一完整囊壁,囊壁与周围组织粘连,完整切除肿物及周围的肉芽组织,灭滴灵生理盐水冲洗伤口,逐层缝合,局部加压包扎。术中切开囊壁,囊内有脓性分泌物及肉芽样组织,留取分泌物送真菌培养及药敏,肿物送组织病理学检查。术后给予哌拉西林钠舒巴坦钠5 g,每日2次静脉滴注治疗3 d,后改为头孢呋辛酯片0.25 g,每日2次口服3 d。术后7 d拆线,伤口愈合好。术中留取肿物囊内分泌物真菌培养结果:近平滑假丝酵母菌(图3);肿物组织病理学回报示:(左鼻前庭)组织局灶呈囊壁样,被覆呼吸性黏膜上皮,慢性炎性反应细胞浸润,PAS染色及GMS染色均未见真菌。于2015年3月5日出院,出院诊断:鼻前庭囊肿合并真菌感染。出院后继续给予抗真菌治疗:氟康唑胶囊150 mg,每日2次口服7 d,后改为150 mg,每日1次口服30 d。术后定期随访,术后1个月患者伤口愈合可(图4)。随访至今1年,无复发。
鼻前庭囊肿是耳鼻咽喉科较为常见的疾病,其发生机制仍存在争论。多数学者认为与腺体潴留或先天性胚胎异常有关;也有学者认为是鼻泪管发育异常所致[1,2]。本病以女性多见,发病年龄多在30~50岁。囊肿生长缓慢,早期无不适症状,伴随发病时间延长,囊肿逐渐增大,可压迫周围神经,产生胀痛感,部分表现为鼻翼软组织下的球形肿物。向前下可压迫鼻前庭部,造成鼻部甚至面部变形,下鼻甲上抬或内移可能会导致鼻塞,穿刺可抽出黄色或棕色液体[3]。CT检查无骨质破坏,但可见骨质受压变形,且囊肿与牙齿无关。鼻前庭囊肿一旦发现应积极采取手术治疗,以免继发感染,造成手术困难。
鼻前庭囊肿反复感染较多见,但伴发真菌感染临床较罕见。本例患者为近平滑假丝酵母菌感染,该菌属假丝酵母属,念珠菌类。近平滑假丝酵母菌是假丝酵母菌属中导致甲癣的第2位病原菌;在马耳他,该菌是导致甲癣最常见的酵母菌[4,5]。该患者有足癣史(不规律治疗,未愈),有抠鼻嗜好,考虑其真菌感染可能与足癣及抠鼻习惯有关。
通过此患者诊疗经过,总结此病例体会如下:(1)养成良好的手卫生习惯,尤其手足癣者,戒除不良抠鼻习惯;(2)由于鼻前庭囊肿合并真菌感染比较罕见,故对于合并感染的患者,建议首先选择抗生素治疗,如果患者局部症状无改善甚至加重,可考虑真菌感染的可能性,但必须先行穿刺或切开引流,抽取分泌物进行培养,明确为真菌感染,方可抗真菌治疗;(3)一旦明确真菌感染,因属于组织内侵犯,应在药敏结果的指导下,选择有效抗真菌药物,感染控制后,再行手术切除囊肿,术后根据培养结果,继续足程足量的抗真菌治疗,并定期随诊。





















